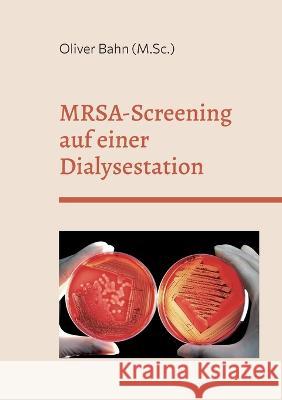
MRSA-Screening auf einer Dialysestation: -Querschnittsstudie zur Prävalenz im Teilstationären Patientenbereich Bahn, Oliver 9783756843343 Books on Demand

» książki » Medical - General
 |
Logogenia para niños sordos: Material para el seguimiento y desarrollo lingüístico del español
ISBN: 9798793201209 / Hiszpański / Miękka / 70 str. Termin realizacji zamówienia: ok. 5-8 dni roboczych. |
cena:
36,28 zł |
 |
Leer y comprender con logogenia: Primeras etapas de desarrollo lingüístico de una niña sorda
ISBN: 9798793201223 / Hiszpański / Miękka / 114 str. Termin realizacji zamówienia: ok. 5-8 dni roboczych. |
cena:
36,28 zł |
 |
The Crowd, A Study of the Popular Mind
ISBN: 9789899880764 / Angielski / Miękka / 180 str. Termin realizacji zamówienia: ok. 5-8 dni roboczych. This book has been professionally retyped and reformatted to fit modern day standards by officials of the Portuguese Institute of Higher Studies in Geopolitics and Auxiliary Sciences. * Organised crowds have always played an important part in the life of peoples, but this part has never been of such moment as at present. The substitution of the unconscious action of crowds for the conscious activity of individuals is one of the principal characteristics of the present age. I have endeavoured to examine the difficult problem presented by crowds in a purely scientific manner-that is, by making...
This book has been professionally retyped and reformatted to fit modern day standards by officials of the Portuguese Institute of Higher Studies in Ge...
|
cena:
36,32 zł |
 |
Diabetic Clarity: Discover Everything There Is To Know About Diabetes Through Diabetic Clarity
ISBN: 9781697474398 / Angielski / Miękka / 56 str. Termin realizacji zamówienia: ok. 5-8 dni roboczych. |
cena:
36,32 zł |
 |
Design Control, Medical Device Risk and Medical Device Regulation (MDR 2017/745): An Integrated Approach for Medical Devices
ISBN: 9798690205256 / Angielski / Miękka / 126 str. Termin realizacji zamówienia: ok. 5-8 dni roboczych. |
cena:
36,32 zł |
 |
Cell phone radiation and damage
ISBN: 9798651555093 / Angielski / Miękka / 176 str. Termin realizacji zamówienia: ok. 5-8 dni roboczych. |
cena:
36,32 zł |
 |
A Brief Guide to Antibody-drug Conjugate
ISBN: 9781974143283 / Angielski / Miękka / 26 str. Termin realizacji zamówienia: ok. 5-8 dni roboczych. |
cena:
36,84 zł |
 |
Teeth Healing through Oil Pulling: The Complete Guide in Natural Oral Care through the Benefits of Oil Pulling
ISBN: 9781512211498 / Angielski / Miękka / 38 str. Termin realizacji zamówienia: ok. 5-8 dni roboczych. Want Priority Access to FREE eBooks Additional Materials for this Book? As we release NEW eBooks, we offer them for FREE for a limited time. You will be the FIRST one to know when they are FREE. Join 1000's of insiders who are getting access to FREE Kindle book promotions weekly. Click HERE for FREE additional material and FREE eBooks- www.rictamilypublishing.com
Want Priority Access to FREE eBooks Additional Materials for this Book? As we release NEW eBooks, we offer them for FREE for a limited time. You will ...
|
cena:
36,92 zł |
 |
Ectopia Cordis
ISBN: 9784598303033 / Arabski / Miękka / 30 str. Termin realizacji zamówienia: ok. 5-8 dni roboczych. |
cena:
36,92 zł |
 |
Petit Glossaire Oto-Rhino Pour Tous
ISBN: 9781726873451 / Francuski / Miękka / 74 str. Termin realizacji zamówienia: ok. 5-8 dni roboczych. |
cena:
36,96 zł |
 |
Qualidade Na Recepção: Encantando O Paciente No Dia a Dia
ISBN: 9788562608063 / Portugalski / Miękka / 122 str. Termin realizacji zamówienia: ok. 5-8 dni roboczych. |
cena:
37,49 zł |
 |
101 Healing Bible verses: Healing Faith Prayer Works
ISBN: 9781999676544 / Angielski Termin realizacji zamówienia: ok. 5-8 dni roboczych. |
cena:
38,04 zł |
 |
Medical Word Find
ISBN: 9781466934238 / Angielski / Miękka / 56 str. Termin realizacji zamówienia: ok. 5-8 dni roboczych. |
cena:
38,09 zł |
 |
The Bullet's Yaw: Reflections on Violence, Healing and an Unforgettable Stranger
ISBN: 9780595476480 / Angielski / Miękka / 72 str. Termin realizacji zamówienia: ok. 5-8 dni roboczych. Jeffrey Mains was in shock.
During a vengeful rampage, a deranged former security guard had fired a hollow point bullet into Mains' truck. The bullet's path through steel slowed its velocity, causing it to tumble sideways when it collided with Mains, a phenomenon that ballistics experts call the "bullet's yaw." The bullet's impact and ensuing yaw were over in a blink, but the effects were profound. Mains' bowel was pierced and leaking, his liver lacerated and one diaphragm ruptured. When the ambulance arrived, Jeffrey Mains was nearly unconscious; he was bleeding internally and desperately... Jeffrey Mains was in shock.
During a vengeful rampage, a deranged former security guard had fired a hollow point bullet into Mains' truck. The bull... |
cena:
38,24 zł |
 |
Stages of Suicide - How to Help Your Mind
ISBN: 9780645277531 / Angielski Termin realizacji zamówienia: ok. 5-8 dni roboczych. |
cena:
38,24 zł |
 |
"Arabic Language Learning By Medical & Paramedical Staff.": 'Supplement-Common Use Arabic.'
ISBN: 9781497356306 / Angielski / Miękka / 124 str. Termin realizacji zamówienia: ok. 5-8 dni roboczych. The Necessity, Of A Text Of Arabic Language Learning, By Non Arabic Speaking Medical And Paramedical Staff, For Dealing Arabic Speaking Persons, Is An Important Need, For All Times. The Present Text, Comprises The Arabic Translation Of Various Relevant Leading Questions, Commands, Requests, Suggestions, Advises And Their Expected Responses, Required By, Medical & Paramedical Personnels, For Conducting Dealing With Arabic Speaking Persons, In Completing Various Necessary Official Formalities, Simultaneously Satisfying, The Necessary Needs, In Regards To Clinical Acumen Of A Clinician, With No...
The Necessity, Of A Text Of Arabic Language Learning, By Non Arabic Speaking Medical And Paramedical Staff, For Dealing Arabic Speaking Persons, Is An...
|
cena:
38,34 zł |
 |
The Asperger Syndrome for Physicians
ISBN: 9783749469833 / Angielski / Miękka / 34 str. Termin realizacji zamówienia: ok. 5-8 dni roboczych. |
cena:
38,34 zł |
|
MRSA-Screening auf einer Dialysestation: -Querschnittsstudie zur Prävalenz im Teilstationären Patientenbereich
ISBN: 9783756843343 / Niemiecki Termin realizacji zamówienia: ok. 5-8 dni roboczych. |
cena:
38,34 zł |
 |
Aforismos Y Sentencias
ISBN: 9781534713673 / Hiszpański / Miękka / 186 str. Termin realizacji zamówienia: ok. 5-8 dni roboczych. El juramento hipocratico, la concepcion de Hipocrates sobre la enfermedad y su minuciosa descripcion de los casos ofrecen una amena ilustracion de la medicina de su epoca. Mejor que cualquier cronica, los relatos de los procesos de salud-enfermedad que este estudioso realiza de sus numerosos pacientes revelan muchas de las nociones fundantes de las ciencias medicas. Ideal para interesados en la medicina y en la antiguedad clasica en general."
El juramento hipocratico, la concepcion de Hipocrates sobre la enfermedad y su minuciosa descripcion de los casos ofrecen una amena ilustracion de la ...
|
cena:
38,34 zł |
 |
The Infant Mortality Rate and the Black Community
ISBN: 9781735624587 / Angielski / Miękka / 90 str. Termin realizacji zamówienia: ok. 5-8 dni roboczych. |
cena:
38,39 zł |













